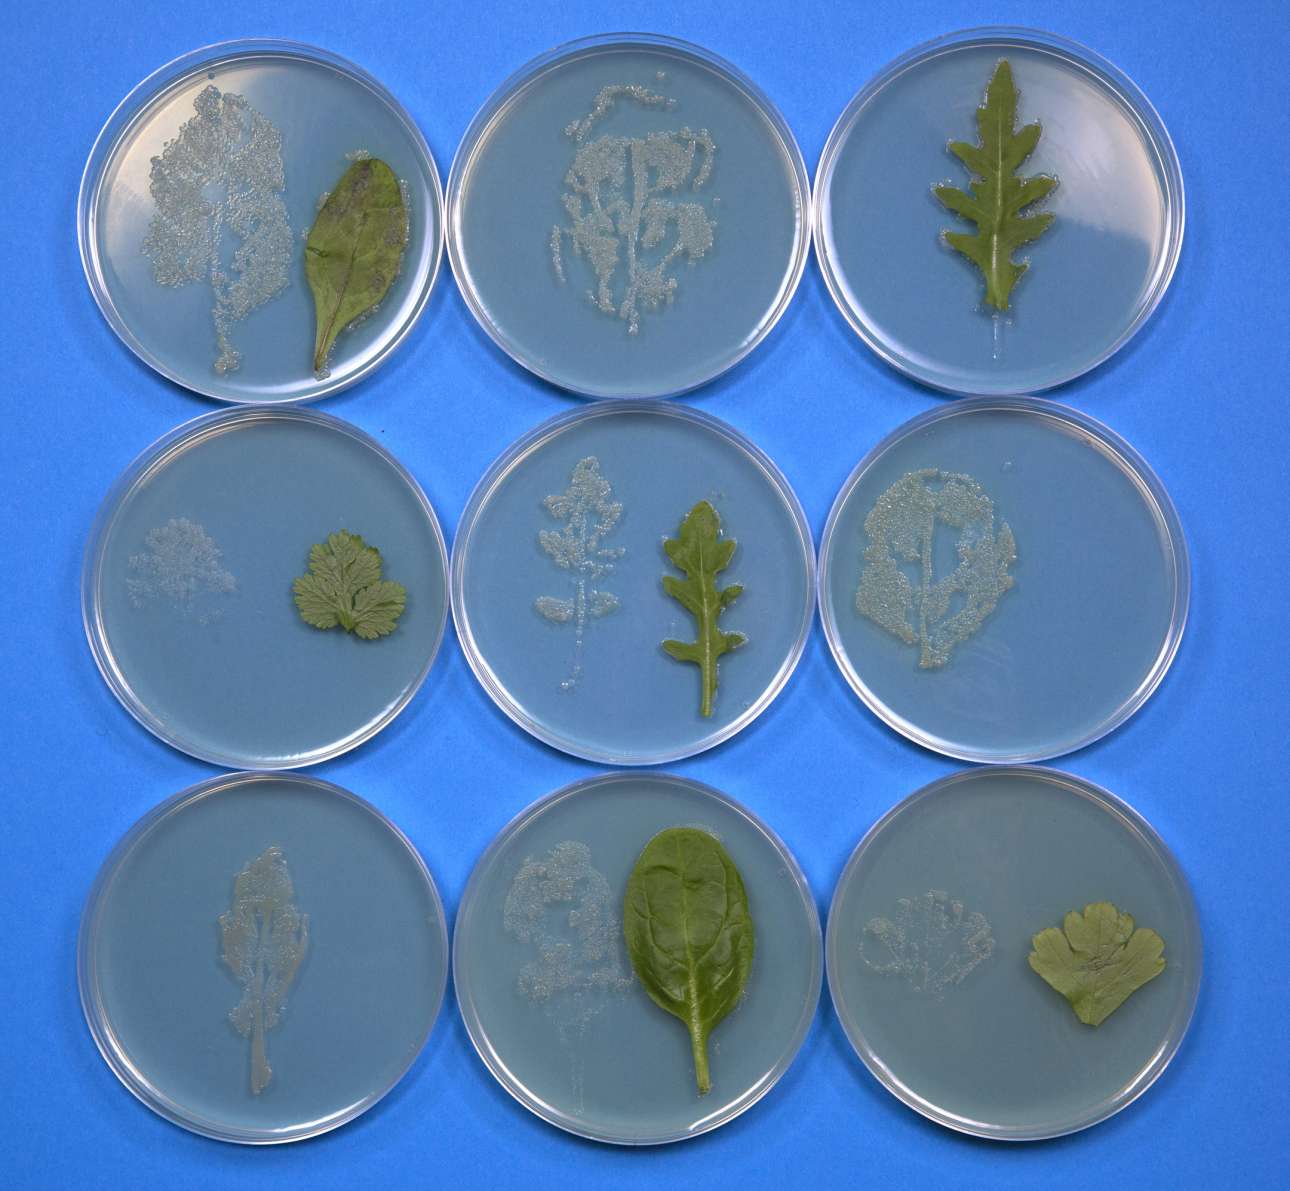

Συσκευασμένες σαλάτες, ένα κρυφό «γήπεδο» για τη σαλμονέλα
Συσκευασμένες σαλάτες, ένα κρυφό «γήπεδο» για τη σαλμονέλα
Μπορεί οι έτοιμες σαλάτες να είναι η εύκολη λύση και είμαστε βέβαιοι ότι η έτοιμη σαλάτα είναι το καλύτερο γρήγορο γεύμα ή η βασική σαλάτα στο τραπέζι μας. Ωστόσο, σε έρευνα που έκανε κύπριος επιστήμονας στο Πανεπιστήμιο του Λέστερ, αποκαλύπτει ότι οι συσκευασμένες σαλάτες είναι το καλύτερο περιβάλλον για την ανάπτυξη σαλμονέλας. Μάλιστα, η παρουσία του επικίνδυνου ακόμη και για τη ζωή βακτηριδίου, μπορεί να είναι 2.400 φορές πιο μολυσματική στις κομμένες και συσκευασμένες σαλάτες από ότι σε άλλα τρόφιμα.
Όπως αποδείχθηκε από τις αναλύσεις που έγιναν στο εργαστήριο του πανεπιστημίου οι χυμοί που αποβάλλονται από τα κομμένα φύλλα έχουν θρεπτικά συστατικά και σε συνδυασμό με την υγρασία αποτελούν το κατάλληλο έδαφος για την ανάπτυξη του μικροοργανισμού.
Την έρευνα έκανε ο διδακτορικός φοιτητής Γιάννης Κουκκίδης με επικεφαλής την μικροβιολόγο δρ. Πριμρόουζ Φριστόουν και δημοσιεύτηκε στην επιστημονική επιθεώρηση Applied and Environmental Microbiology.

Οι επιστήμονες ανακάλυψαν ότι ακόμη και μικροποσότητες χυμού όχι μεγαλύτερες από το ένα διακοσιοστό ενός κουταλιού του γλυκού που προέρχονται από τα κομμένα φύλα σαλάτας ή σπανακιού και μένουν μέσα στην πλαστική σακούλα, διευκολύνουν τη σαλμονέλα να πολλαπλασιάσει τα βακτήριά της, ακόμη κι όταν η συσκευασία βρίσκεται στο ψυγείο.
Μάλιστα, το βακτήριο προσκολλάται τόσο γερά στα κομμένα φύλλα, που δεν φεύγει ούτε με καλό πλύσιμο. Αρκούν λίγα κύτταρα σαλμονέλας στην αρχή της συσκευασίας για να έχουν αυξηθεί σε πολλές χιλιάδες, μέχρι να καταναλώσουμε το προϊόν ακόμη και πριν από την ημερομηνία λήξης του. Τα αρχικά 100 βακτήρια σαλμονέλας μπορούν να γίνουν 100.000 μέσα σε πέντε μόνο μέρες από το αρχικό κόψιμο της σαλάτας.
Οι ερευνητές επεσήμαναν την ανάγκη τα κομμένα και συσκευασμένα φρέσκα λαχανικά να τρώγονται όσο γίνεται πιο γρήγορα μετά το άνοιγμά τους. Κι αυτό διότι μόλις ανοίξει η σακούλα, τα βακτήρια της σαλμονέλας αναπτύσσονται ακόμη πιο γρήγορα από ό,τι όταν βρίσκονται στο ψυγείο. Μάλιστα, οι ερευνητές βρήκαν ότι η σαλμονέλα είναι δυνατό να αναπτυχθεί ακόμη κι όταν η ψύξη του ψυγείου βρίσκεται στους 4 βαθμούς Κελσίου και όχι στους 5,2 βαθμούς, όπως πιστευόταν έως τώρα.
Η μόλυνση των σαλατών και λαχανικών από σαλμονέλα μπορεί να συμβεί από την επαφή τους με ζώο ή έντομο, από το χώμα, από μολυσμένο νερό κατά την άρδευση του χωραφιού ή από μολυσμένο εξοπλισμό ή μολυσμένα χέρια εργαζομένων κατά την κοπή και συσκευασία του προϊόντος.
Σε κάθε περίπτωση, σύμφωνα με τους ειδικούς, όλα τα φρέσκα προϊόντα, συσκευασμένα και μη, χρειάζονται πολύ καλό πλύσιμο, προτού καταναλωθούν. Συνήθως οι συσκευασμένες σαλάτες έχουν προηγουμένως πλυθεί με χλωριωμένο νερό. Το χλώριο μειώνει μεν την παρουσία των παθογόνων μικροοργανισμών, αλλά δεν την εξαλείφει.
Οι ερευνητές συστήνουν στους καταναλωτές να αγοράζουν σαλάτες που έχουν πρόσφατα κοπεί και να τις τρώνε αυθημερόν. Ερευνητές στις ΗΠΑ που έχουν κάνει δειγματοληψίες, βρήκαν ότι το 0% έως 3% των συσκευασμένων σαλατών είναι μολυσμένες, σύμφωνα με το BBC.

Ποιος είναι ο Γιάννης Κουκκίδης
Ο Γιάννης Κουκκίδης γεννήθηκε στη Λεμεσό της Κύπρου. Αποφοίτησε από το Λύκειο Λινόπετρας το 2007 και στη συνέχεια μετέβη στην Αγγλία για να σπουδάσει Βιολογικές Επιστήμες στο Πανεπιστήμιο του Λέστερ. Αφού ολοκλήρωσε τις μεταπτυχιακές του σπουδές στην Λοίμωξη και Ανοσολογία το 2013 εξασφάλισε υποτροφία για διδακτορικό στο Πανεπιστήμιο του Λέστερ από το Συμβούλιο Βιοτεχνολογίας και Βιολογικών Επιστημών του Ηνωμένου Βασιλείου (BBSRC) και το Campden BRI UK. Το θέμα της διατριβής του αφορά την ασφάλεια τροφίμων και τις αλληλεπιδράσεις εντεροπαθογόνων οργανισμών όπως Σαλμονέλα και E. coli με τις σαλάτες και τα λαχανικά, όπου και διανύει τώρα τον τρίτο του χρόνο. Ο Γιάννης στον ελεύθερο του χρόνο ασχολείται με τον αθλητισμό, το τραγούδι και την κιθάρα.
Ακολουθήστε το Protagon στο Google News







